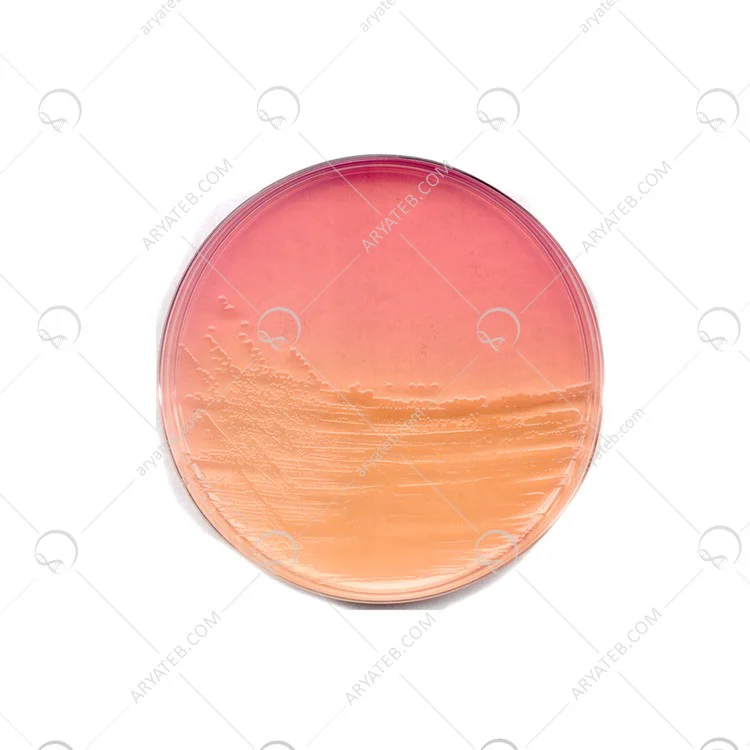

محیط کشت endu agar
اکثرا محیط افتراقی رو به انتخابی محسوب میشود مناسب به کار گیری و نظارت بر رشد میکروارگانیسم های روده دارد که به نوعی تشخیص دهنده ی فرم ها محسوب میشود
کارایی فرم میکروارگانیسم روده بر پایه نمک صفراوی استوار می باشد نام محیط کشت برگرفته از فردیست که طی سال ها به این نتیجه رسید که میکروارگانیسم ها بدون نمک صفراوی قادر به تخمیر لاکتوز میباشد این دانشمند اندو نام داشت که این محیط را به نام خود نامگذاری کرد
گاهی نیاز به مهار میکروارگانیسم میباشد که با افزودن دو نوع محلول پایه مثل فوشین و سولفات سدیم می توان محیط نسبتا پایه ای را تشکیل دارد
در ابتدا برای شناسایی باسیلوس تیفوئید و تشخیصش بیشتر استفاده می شود.
انتخاب این محیط کشت تخمیر لاکتوز را به عقب و محتوای بی رنگ بنفشی تولید میکند.
البته ph مد نظر قبل کشت این محیط باید تعیین شود زیرا یک موضوع ضروری میباشد .
محیط کشت رشد میکروبیولوژیکی با رنگ صورتی ضعیف میباشد .
از ابتدا جدا کننده ی سالمونلا تیفی بوده که هنگام افزایش توسعه اکنون به محیط کلیفرم تبدیل شده است رشد ارگانیسم گرم منفی برای این محیط بسیار عالی می باشد
یک وسیله انتخابی تشکیلی از ویتامین ها و مواد معدنی میباشد
اگر محیط رشد خوبی نداشته باشد ممکن است که باکتری گرم مثبت درون خود داشته باشد که سبب ضعف رشد شده .
برای دیدن انواع محیط کشت کلیلک کنید
مواد تشکیل دهنده محیط کشت اندو آگار
طرز تهیه و ساخت محیط کشت Endo Agar
- 41.5 گرم اندو آگار را در 1000 میلی لیتر آب مقطر معلق کنید.
- آن را حرارت دهید تا محیط کاملاً در آب حل شود.
- با اتوکلاو در دمای 121 درجه سانتیگراد به مدت 15 دقیقه استریل کنید.
- قبل از ریختن در پتری ظروف استریل خوب مخلوط کنید.
تفسیر نتیجه در Endo Agar
فروش محیط کشت اندو آگار
شرکت آریا طب آماده ارائه انواع محیط های کشت باکتری و سایر میکروارگانیسم ها می باشد. فروش محیط کشت اندو با کیفیت بالا و قیمت مناسب به صورت اینترنتی انجام می شود.
محیط کشت اندو به عنوان محیطی مناسب برای تشخیص کلی اشکال روده ای و میکروارگانیسم ها محسوب می شود. محیط کشت اندو، بر خلاف برخی از محیط های کشت دیگر، می تواند لاکتوز را بدون نمک های صفراوی تخمیر کند و باکتری ها و میکروارگانیسم های قادر به تخمیر را می توان شناسایی و جدا کرد. اگر لاکتوز در محیط تخمیر شود، رنگ کلنی ها به سمت قرمز متمایل می شود، در غیر این صورت کلنی های بی رنگ در پس زمینه دیده می شوند.
ویژگی های محیط کشت اندو آگار
- عدم وجود نمک های صفراوی
- یک محیط متفاوت و تا حدودی انتخابی
کاربردهای محیط کشت اندو آگار
- شناسایی کلی و تفکیک فرم ها
- تشخیص میکروارگانیسم های روده
- مهار رشد باکتری های گرم مثبت
محیط کشت اندو آگار را بخرید
فروشگاه آریا طب مفتخر است که انواع محیط های کشت ساخت مرک آلمان را با کیفیت بالا و قیمت مناسب به فروش می رساند. محیط کشت اندو آگار را می توان به صورت آنلاین از آریا طب خریداری کرد و پس از ثبت نام و پرداخت به منزل شما ارسال می شود. در صورت بروز هرگونه مشکل و یا کسب اطلاعات بیشتر با کارشناسان مجموعه آریا طب تماس حاصل فرمایید.
موارد استفاده از محیط کشت اندو آگار
- این محیط در حال حاضر برای افتراق ارگانیسمهای رودهای تخمیرکننده لاکتوز از ارگانیسمهای رودهای تخمیرکننده لاکتوز، بهویژه هنگام تأیید آزمایش پیشفرض برای کلیفرمها استفاده میشود.
- Endo Agar توسط APHA به عنوان یک ماده مهم در مطالعه میکروبیولوژیکی آب و فاضلاب، محصولات لبنی و غذاها توصیه می شود.
- Endo Agar برای تایید تشخیص و تعداد باکتری های کلیفرم پس از آزمایش احتمالی آب آشامیدنی استفاده می شود.
- همچنین برای تشخیص و جداسازی کلیفرم ها و کلیفرم های مدفوعی از شیر، محصولات لبنی و غذا استفاده می شود.
- از محیط کشت اندو آگار برای شمارش کلیفرم ها در آب با فیلتراسیون غشایی در شرایط آزمایشگاهی استفاده می شود.
آدرس ایمیل شما منتشر نخواهد شد. فیلدهای الزامی علامت گذاری شده اند *